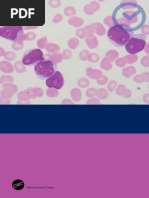

Cardiac Cycle Events
Ventricular Filling
THE CARDIAC CYCLE
Isovolumetric Contraction Isovolumetric Contraction Ventricular Ejection
ATRIAL SYSTOLE
The end of diastole
�ATRIAL SYSTOLE ECG
ATRIAL SYSTOLE - Heart
Prior to atrial systole, blood has been flowing passively from the atrium into the ventricle through the open AV valve. During atrial systole the atrium contracts and tops off the volume in the ventricle with only a small amount of blood. Atrial contraction is complete before the ventricle begins to contract.
An impulse arising from the SA node results in depolarization and and contraction of the atria (the right atrium contracts slightly before the before left atrium). The P wave is due to this atrial depolarization. The PR segment is electrically quiet as the depolarization proceeds proceeds to the AV node. This brief pause before contraction allows the ventricles to fill fill completely with blood.
ATRIAL SYSTOLE Pressures & Volumes
The "a" wave occurs when the atrium contracts, increasing atrial pressure (yellow). Blood arriving at the heart cannot enter the atrium so it flows back up the jugular vein, causing the first discernible wave in the jugular venous pulse. Atrial pressure drops when the atria stop contracting. During atrial systole the atrium contracts and tops off the volume in the ventricle with only a small amount of blood. Atrial contraction is complete before the ventricle begins to contract.
ATRIAL SYSTOLE Heart Sounds
A fourth heart sound (S4) is abnormal and is associated with the end of atrial emptying after atrial contraction. It occurs with hypertrophic congestive heart failure, massive pulmonary embolism, tricuspid incompetence, or cor pulmonale. pulmonale.
ISOVOLUMETRIC CONTRACTION ECG
ISOVOLUMETRIC CONTRACTION
The electrical impulse propagates from the AV node through the His His bundle and Purkinje system to allow the ventricles to contract from from the apex of the heart towards the base. The QRS complex is due to ventricular depolarization, and it marks marks the beginning of ventricular systole. It is so large that it masks the masks underlying atrial repolarization signal. the ventricles to fill completely with blood.
The Beginning of systole
�ISOVOLUMETRIC CONTRACTION Heart
The atrioventricular (AV) valves close at the beginning of this phase. Electrically, ventricular systole is defined as the interval between the QRS complex and the end of the T wave (the Q-T interval). QMechanically, ventricular systole is defined as the interval between the closing of the AV valves and the opening of the semilunar valves (aortic and pulmonary valves).
ISOVOLUMETRIC CONTRACTION Pressures & Volumes
The AV valves close when the pressure in the ventricles (red) exceeds the pressure in the atria (yellow). As the ventricles contract isovolumetrically -- their volume does not change (white) -- the pressure inside increases, approaching the pressure in the aorta and pulmonary arteries (green).
ISOVOLUMETRIC CONTRACTION Heart Sounds
RAPID EJECTION
The first heart sound (S1, "lub") is due to the closing AV valves and "lub") associated blood turbulence.
RAPID EJECTION ECG
RAPID EJECTION Heart
The semilunar (aortic and pulmonary) valves open at the beginning of this phase.
No Deflections
�RAPID EJECTION Pressures & Volumes
While the ventricles continue contracting, the pressure in the ventricles (red) exceeds the pressure in the aorta and pulmonary arteries (green); the semilunar valves open, blood exits the ventricles, and the volume in the ventricles decreases rapidly (white). As more blood enters the arteries, pressure there builds until the flow of blood reaches a peak. The "c" wave of atrial pressure is not normally discernible in the jugular venous pulse. Right ventricular contraction pushes the tricuspid valve into the atrium and increases atrial pressure, creating a small wave into the jugular vein. It is normally simultaneous with the carotid pulse.
RAPID EJECTION Heart Sounds
None
REDUCED EJECTION ECG
REDUCED EJECTION
The end of systole
The T wave is due to ventricular repolarization. The end of the repolarization. T wave marks the end of ventricular systole electrically.
REDUCED EJECTION Heart
At the end of this phase the semilunar (aortic and pulmonary) valves close.
REDUCED EJECTION Pressures & Volumes
After the peak in ventricular and arterial pressures (red and green), blood flow out of the ventricles decreases and ventricular volume decreases more slowly (white). When the pressure in the ventricles falls below the pressure in the arteries, blood in the arteries begins to flow back toward the ventricles and causes the semilunar valves to close. This marks the end of ventricular systole mechanically.
�REDUCED EJECTION Heart Sounds
ISOVOLUMETRIC RELAXATION
None
The beginning of Diastole
ISOVOLUMETRIC RELAXATION ECG
ISOVOLUMETRIC RELAXATION Heart
At the beginning of this phase the AV valves are closed.
No Deflections
ISOVOLUMETRIC RELAXATION Pressures & Volumes
Throughout this and the previous two phases, the atrium in diastole has been filling with blood on top of the closed AV valve, causing atrial pressure to rise gradually (yellow). The "v" wave is due to the back flow of blood after it hits the closed AV valve. It is the second discernible wave of the jugular venous pulse. The pressure in the ventricles (red) continues to drop. Ventricular volume (white) is at a minimum and is ready to be filled again with blood.
ISOVOLUMETRIC RELAXATION Heart Sounds
The second heart sound (S2, "dup") occurs when the semilunar (aortic and pulmonary) valves close. S2 is normally split because the aortic valve closes slightly earlier than the pulmonary valve.
�RAPID VENTRICULAR FILLING Heart
RAPID VENTRICULAR FILLING
Once the AV valves open, blood that has accumulated in the atria flows rapidly into the ventricles.
RAPID VENTRICULAR FILLING Pressures & Volumes
Ventricular volume (white) increases rapidly as blood flows from the atria into the ventricles.
RAPID VENTRICULAR FILLING ECG
No Deflections
RAPID VENTRICULAR FILLING Heart Sounds
REDUCED VENTRICULAR FILLING
A third heart sound (S3) is usually abnormal and is due to rapid passive ventricular filling. It occurs in dilated congestive congestive heart failure, severe hypertension, myocardial infarction, or mitral incompetence.
(Diastasis) Diastasis)
�REDUCED VENTRICULAR FILLING Heart
Rest of blood that has accumulated in the atria flows slowly into the ventricles.
REDUCED VENTRICULAR FILLING Pressures & Volumes
Ventricular volume (white) increases more slowly now. The ventricles continue to fill with blood until they are nearly full.
REDUCED VENTRICULAR FILLING ECG
REDUCED VENTRICULAR FILLING Heart Sounds
No Deflections
None
THE COMPLETE PICTURE
Summary